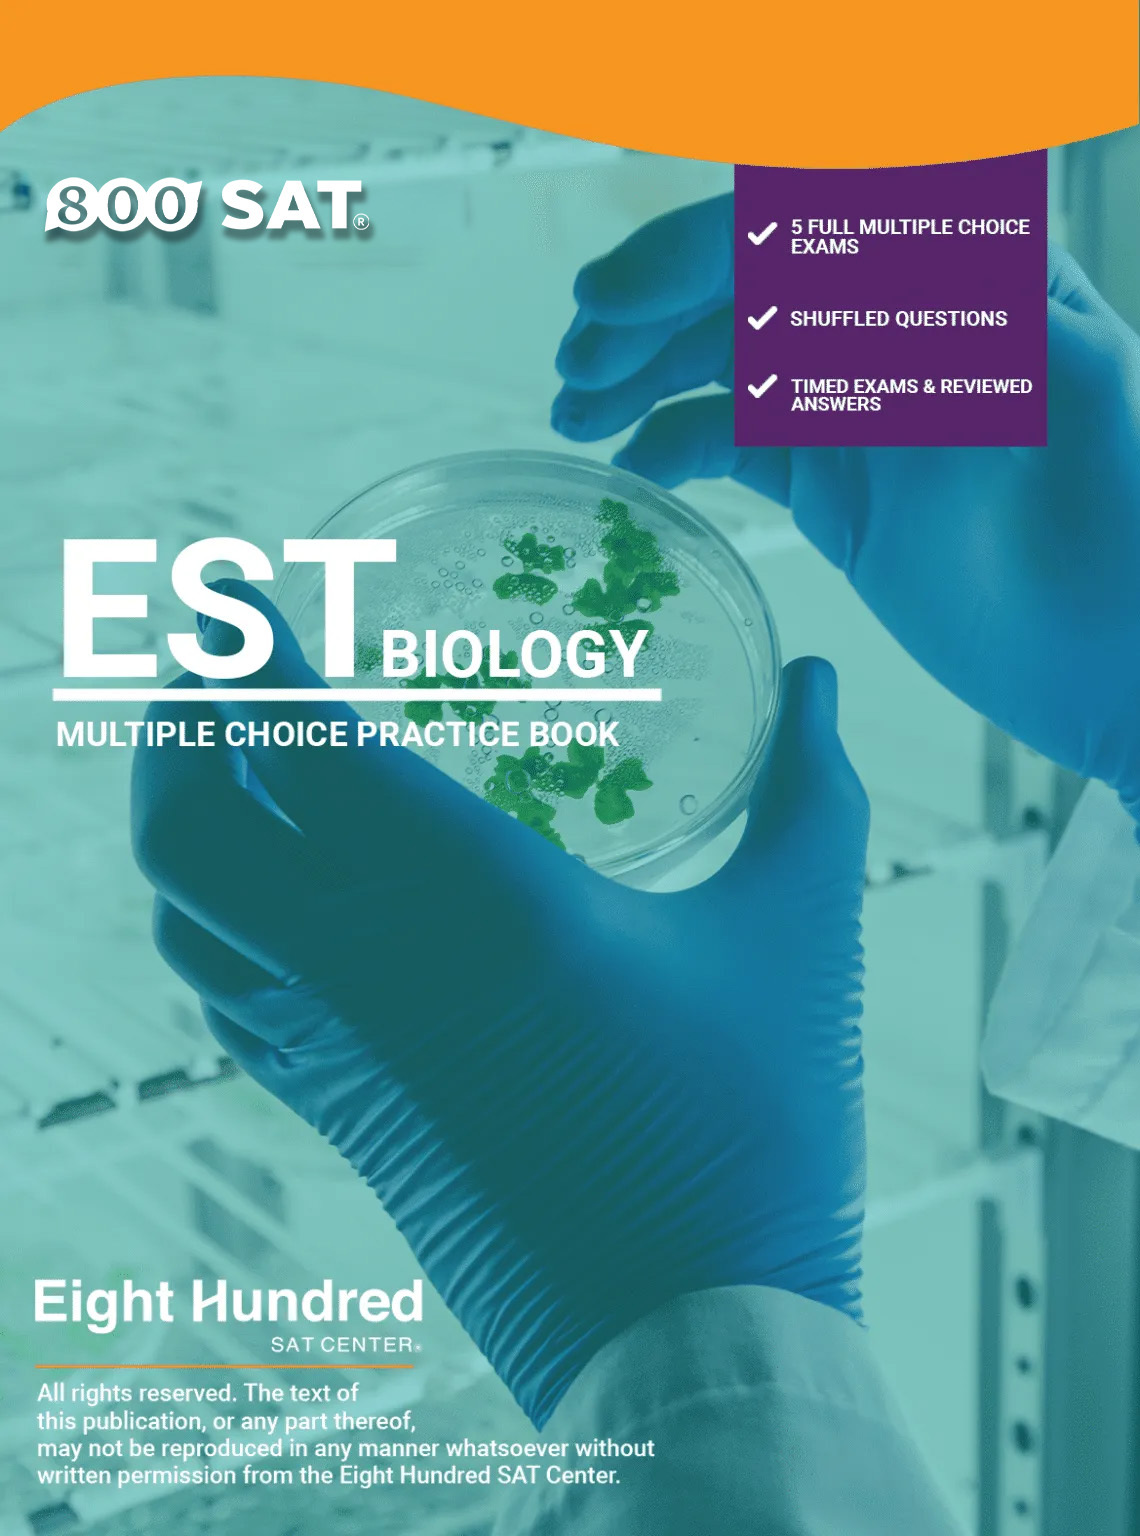

This study guide is divided into three parts, allowing you the flexibility to choose either a single part or engage with all parts
This study guide is divided into three parts, allowing you the flexibility to choose either a single part or engage with all parts
This study guide is divided into three parts, allowing you the flexibility to choose either a single part or engage with all parts
لمن هذا النظام؟
.لطلاب المدارس من الصف الأول وحتى الصف الثامن لكلا البرنامجين الوطني والأجنبي –
النظام شهري (حصتين بالأسبوع) مدة الحصة الواحدة ساعة ونصف-
:الهدف من هذا النظام
يهدف نظام التقوية والمتابعة المدرسية إلى متابعة واجبات الطالب والتركيز على نقاط الضعف عنده ومساعدة الأهل في تطوير إمكانيات الطالب الأكاديمية والاجتماعية
كيف يعمل نظام المتابعة المدرسية؟
في هذا النظام يكون الطالب مع مجموعة صغيرة من الطلبة المسجلين في نظام التقوية والمتابعة حيث يقوم المعلم أوالمعلمة بمتابعة الواجبات المدرسية أو التحضير للامتحانات القصيرة والتركيز على نقاط ضعف كل طالب
| Day | Time |
| Saturday | (12:00 – 1:30 pm) |
| Monday | (4:30 – 6:00 pm) |
| Tuesday | (4:30 – 6:00 pm) |
يكون الحضورللطلبة وجاهيا فقط, وفي حالة التغيب فهي حرية الطالب (لا يتم تأجيل او الغاء الحصص) لأنه نظام جماعي
:الاشتراك شهري
للشهر الواحد:100 دينار
للشهرين: 175 دينار
للثلاث أشهر: 225 دينار
:معلومات هامة
- مدة الحصة ساعة ونصف.
- مدة الدورة: 20 حصة (المسار العادي)او 10 حصص (المسار المكثف) على حسب اختيار الطالب
هذه الدورة لمن؟ (دورة تحضيرية لامتحان الايلتس)
- اذا كنت تسعى لتحقيق أعلى امكانياتك في امتحانات الايلتس مع معلم خصوصي يغطي لك المادة حسب احتياجاتك الفردية ويركز على نقاط ضعفك ويعمل على تحسينها.
- لمن لديهم أساس جيد في اللغة ويسعون للتعرف على استراتيجيات حل الامتحان ومهارة إدارة الوقت.
لماذا يجب عليك أن تختار الدورة الفردية؟
- سيزودك معلمك بتقرير عن أدائك بشكل متواصل خلال الدورة , سيتم التواصل معك من قسم شؤون الطلبة من خلال live chat على تطبيق الهاتف وسيقوم معلمك بحل أسئلة سنوات سابقة لتقييمك وتحسين مستواك.
كيفية الحجز
- قم بإضافة الدورة الي السلة وأكمل عملية الشراء.
- سيقوم قسم IT بإنشاء اسم مستخدم وكلمة مرور جديدة لك على تطبيق 800SAT للهواتف المحمولة.
- سيتم إضافة نقاط الحصص إلى حسابك لتمكينك من حجز الدروس في الوقت والتاريخ الذي تختاره.
Course is designed for students looking to breeze through AP material quickly or for a solid review, this group course runs for 30 hours.
Course duration: February 10th – February 29th, 2024.
It’s all about diving into AP material revision – no time for basics. Join us for a fast and effective prep sessions!
Course price includes:
- LIVE Sessions – Classes are three times per week.
- Written summarized and simplified AP material + assignments (Study Guides)